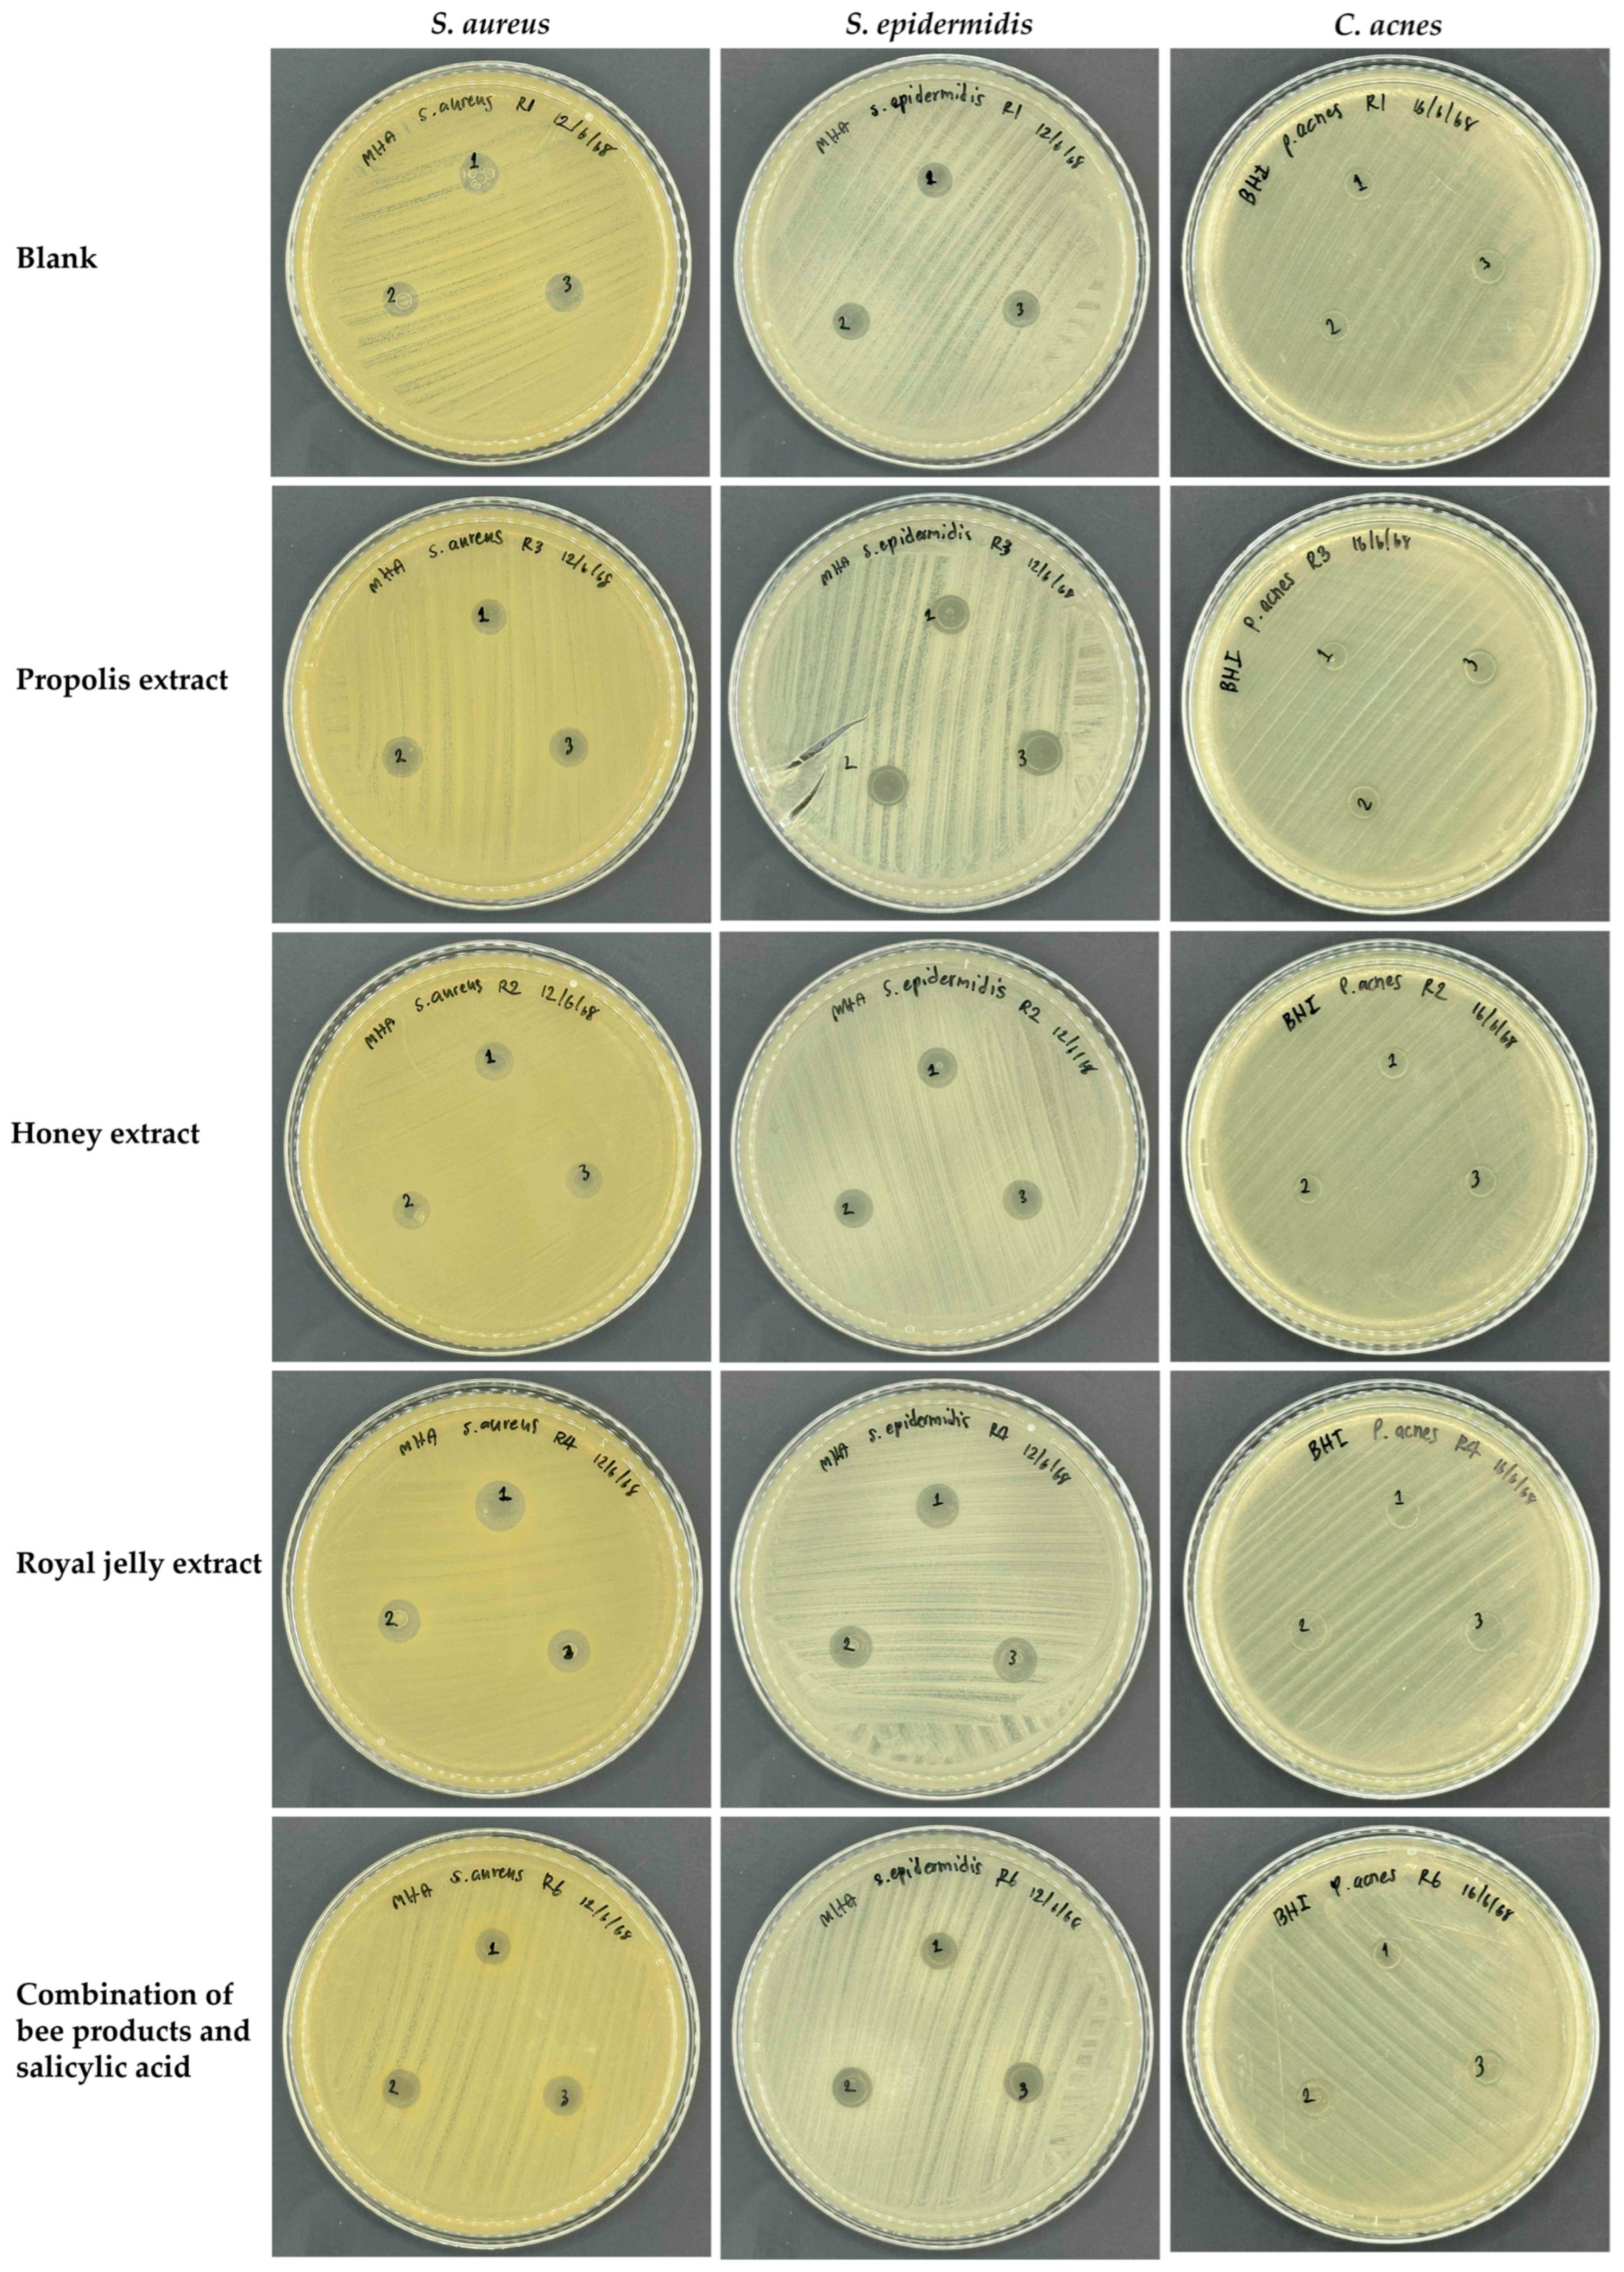
Gels 11 00802 g003 Gels 11 00802 g003

Bee Product-Based Antimicrobial Film-Forming Gels Targeting Staphylococcus aureus, Staphylococcus epidermidis, and Cutibacterium acnes for Anti-Acne Applications
Abstract
1. Introduction
2. Results and Discussion
2.1. Antimicrobial Properties of Bee Products
2.2. Blank Film-Forming Gel
2.3. Film-Forming Gel Containing Bee Products
2.4. Antimicrobial Properties of Film-Forming Gel Containing Bee Products
3. Conclusions
4. Materials and Methods
4.1. Bee Products and Chemical Materials
4.2. Antimicrobial Test of Bee Products
4.3. Development of Blank Film-Forming Gel
4.3.1. Preparation of Blank Film Forming Gel
4.3.2. Characterization of Physical Characterization of Blank Film-Forming Gels
4.3.3. Evaluation of Film Properties of Blank Film-Forming Gels
4.4. Development of Film-Forming Gel Containing Bee Products
4.5. Antimicrobial Test of Film-Forming Gel Containing Bee Products
4.6. Statistical Analysis
Author Contributions
Funding
Institutional Review Board Statement
Informed Consent Statement
Data Availability Statement
Acknowledgments
Conflicts of Interest
Abbreviations
| ANOVA | analysis of variance |
| BHI | Brain heart infusion |
| DMSO | Dimethyl sulfoxide |
| HEC | Hydroxyethyl cellulose |
| HPMC | Hydroxypropyl methylcellulose |
| MHA | Mueller–Hinton agar |
| MHB | Mueller–Hinton broth |
| PEG 400 | Polyethylene glycol 400 |
| PVA | Polyvinyl alcohol |
| PVP | Polyvinylpyrrolidone |
| SD | standard deviation |
References
- AlKhabbaz, M.; Al-Taiar, A.; Saeed, M.; Al-Sabah, R.; Albatineh, A.N. Predictors of acne vulgaris among adolescents in Kuwait. Med. Princ. Pract. 2020, 29, 310–317. [Google Scholar] [CrossRef]
- Tuchayi, S.M.; Makrantonaki, E.; Ganceviciene, R.; Dessinioti, C.; Feldman, S.R.; Zouboulis, C.C. Acne vulgaris. Nat. Rev. Dis. Primers 2015, 1, 1–20. [Google Scholar] [CrossRef]
- Alsaadoon, N.S.J.; Al-Refaie, A.M.; Habashy, A.Y. Acne vulgaris in adolescents: A comprehensive review. Benha J. Appl. Sci. 2024, 9, 5–13. [Google Scholar] [CrossRef]
- Dagnelie, M.A.; Corvec, S.; Timon-David, E.; Khammari, A.; Dréno, B. Cutibacterium acnes and Staphylococcus epidermidis: The unmissable modulators of skin inflammatory response. Exp. Dermatol. 2022, 31, 406–412. [Google Scholar] [CrossRef]
- Fournière, M.; Latire, T.; Souak, D.; Feuilloley, M.G.; Bedoux, G. Staphylococcus epidermidis and Cutibacterium acnes: Two major sentinels of skin microbiota and the influence of cosmetics. Microorganisms 2020, 8, 1752. [Google Scholar] [CrossRef]
- Jaiswal, S.; Jawade, S.; Madke, B.; Gupta, S.; Gupta, S.N. Recent trends in the management of acne vulgaris: A review focusing on clinical studies in the last decade. Cureus 2024, 16, e56596. [Google Scholar] [CrossRef]
- Akhavan, A.; Bershad, S. Topical acne drugs: Review of clinical properties, systemic exposure, and safety. Am. J. Clin. Dermatol. 2003, 4, 473–492. [Google Scholar] [CrossRef]
- Schwartz, R.A.; Al Mutairi, N. Topical antibiotics in dermatology: An update. Glob. J. Dermatol. Venereol. 2010, 17, 1–19. [Google Scholar]
- Dumitru, C.D.; Neacsu, I.A.; Grumezescu, A.M.; Andronescu, E. Bee-derived products: Chemical composition and applications in skin tissue engineering. Pharmaceutics 2022, 14, 750. [Google Scholar] [CrossRef]
- Bava, R.; Castagna, F.; Lupia, C.; Poerio, G.; Liguori, G.; Lombardi, R.; Naturale, M.D.; Bulotta, R.M.; Biondi, V.; Passantino, A.; et al. Hive products: Composition, pharmacological properties, and therapeutic applications. Pharmaceuticals 2024, 17, 646. [Google Scholar] [CrossRef]
- Bruschi, L.; Pereira, R.d.A.; Francisco, L.M.B. The use of propolis in micro/nanostructured pharmaceutical formulations. Recent Pat. Drug Deliv. Formul. 2016, 10, 130–140. [Google Scholar] [CrossRef]
- Ali, B.M.M.; Ghoname, N.F.; Hodeib, A.A.; Elbadawy, M.A. Significance of topical propolis in the treatment of facial acne vulgaris. Egypt. J. Dermatol. Venerol. 2015, 35, 29–36. [Google Scholar] [CrossRef]
- Athanasopoulou, S.; Panagiotidou, E.; Spanidi, E.; Gkika, M.; Georgiou, D.; Anagnostopoulos, A.K.; Ganos, C.; Chinou, I.; Beletsiotis, E.; Gardikis, K. Propolis extract with activity against Cutibacterium acnes biofilm targeting the expression of virulence genes. Antioxidants 2025, 14, 849. [Google Scholar] [CrossRef]
- Naim Tuan Ismail, T.N.; Sulaiman, S.A.; Ponnuraj, K.T.; Hassan, M.T.; Hassan, N.B. Antimicrobial activity of Malaysian Apis mellifera propolis against Propionibacterium acnes. Malays. J. Med. Health Sci. 2022, 18, 171. [Google Scholar]
- Almasaudi, S. The antibacterial activities of honey. Saudi J. Biol. Sci. 2021, 28, 2188–2196. [Google Scholar] [CrossRef]
- Yupanqui Mieles, J.; Vyas, C.; Aslan, E.; Humphreys, G.; Diver, C.; Bartolo, P. Honey: An advanced anti-microbial and wound healing biomaterial for tissue engineering applications. Pharmaceutics 2022, 14, 1663. [Google Scholar] [CrossRef]
- Pasupuleti, V.R.; Sammugam, L.; Ramesh, N.; Gan, S.H. Honey, propolis, and royal jelly: A comprehensive review of their biological actions and health benefits. Oxid. Med. Cell. Longev. 2017, 2017, 1259510. [Google Scholar] [CrossRef]
- Julianti, E.; Rajah, K.K.; Fidrianny, I. Antibacterial activity of ethanolic extract of cinnamon bark, honey, and their combination effects against acne-causing bacteria. Sci. Pharm. 2017, 85, 19. [Google Scholar] [CrossRef]
- Uthaibutra, V.; Kaewkod, T.; Prapawilai, P.; Pandith, H.; Tragoolpua, Y. Inhibition of skin pathogenic bacteria, antioxidant and anti-inflammatory activity of royal jelly from northern Thailand. Molecules 2023, 28, 996. [Google Scholar] [CrossRef]
- Tanngoen, P.; Lamlertthon, S.; Tiyaboonchai, W. Characterization and evaluation of α-mangostin-loaded film-forming gels for acne treatment. Indian J. Pharm. Sci. 2020, 82, 157–165. [Google Scholar] [CrossRef]
- Kathe, K.; Kathpalia, H. Film forming systems for topical and transdermal drug delivery. Asian J. Pharm. Sci. 2017, 12, 487–497. [Google Scholar] [CrossRef]
- Tran, T.T.; Tran, P.H. Controlled release film forming systems in drug delivery: The potential for efficient drug delivery. Pharmaceutics 2019, 11, 290. [Google Scholar] [CrossRef]
- Charitakis, A.; Assi, S.; Yousaf, S.; Khan, I. Overcoming skin damage from pollution via novel skincare strategies. Curr. Pharm. Des. 2022, 28, 1250–1257. [Google Scholar] [CrossRef]
- Zheng, Y.; Wan, M.; Chen, H.; Ye, C.; Zhao, Y.; Yi, J.; Xia, Y.; Lai, W. Clinical evidence on the efficacy and safety of an antioxidant optimized 1.5% salicylic acid (SA) cream in the treatment of facial acne: An open, baseline-controlled clinical study. Skin Res. Technol. 2013, 19, 125–130. [Google Scholar] [CrossRef]
- Jang, H.R.; Kim, S.G.; Hong, I.P.; Woo, S.O.; Han, S.M. Antimicrobial activity of propolis extracts against skin pathogens. J. Apic. 2015, 30, 61–66. [Google Scholar] [CrossRef]
- Israili, Z.H. Antimicrobial properties of honey. Am. J. Ther. 2014, 21, 304–323. [Google Scholar] [CrossRef]
- McLoone, P.; Warnock, M.; Fyfe, L. Honey: A realistic antimicrobial for disorders of the skin. J. Microbiol. Immunol. Infect. 2016, 49, 161–167. [Google Scholar] [CrossRef]
- Bagameri, L.; Baci, G.M.; Dezmirean, D.S. Royal jelly as a nutraceutical natural product with a focus on its antibacterial activity. Pharmaceutics 2022, 14, 1142. [Google Scholar] [CrossRef]
- Madan, R.K.; Levitt, J. A review of toxicity from topical salicylic acid preparations. J. Am. Acad. Dermatol. 2014, 70, 788–792. [Google Scholar] [CrossRef]
- Babayeva, L.; Akarsu, S.E.V.G.İ.; Fetil, E.; Güneş, A.T. Comparison of tretinoin 0.05% cream and 3% alcohol-based salicylic acid preparation in the treatment of acne vulgaris. J. Eur. Acad. Dermatol. Venereol. 2011, 25, 328–333. [Google Scholar] [CrossRef]
- Arif, T. Salicylic acid as a peeling agent: A comprehensive review. Clin. Cosmet. Investig. Dermatol. 2015, 8, 455–461. [Google Scholar] [CrossRef]
- Librando, A.; Carlesimo, S.C.; Albanese, G.; Albanese, G.M.; Migliorini, R.; Pacella, E. Effectiveness of 0.1% topical salicylic acid on blepharoconjunctivitis affecting glaucoma patients treated with topical prostaglandin analogues: A prospective randomized trial. Int. J. Ophthalmol. 2018, 11, 1936. [Google Scholar] [CrossRef]
- Liang, X.; Zhong, H.-J.; Ding, H.; Yu, B.; Ma, X.; Liu, X.; Chong, C.-M.; He, J. Polyvinyl alcohol (PVA)-based hydrogels: Recent progress in fabrication, properties, and multifunctional applications. Polymers 2024, 16, 2755. [Google Scholar] [CrossRef]
- Suleiman, G.S.A.; Zeng, X.; Chakma, R.; Wakai, I.Y.; Feng, Y. Recent advances and challenges in thermal stability of PVA-based film: A review. Polym. Adv. Technol. 2024, 35, e6327. [Google Scholar] [CrossRef]
- Liu, C.; Xiao, C.; Liang, H. Properties and structure of PVP–lignin “blend films”. J. Appl. Polym. Sci. 2005, 95, 1405–1411. [Google Scholar] [CrossRef]
- Deghiedy, N.M.; El-Sayed, S.M. Evaluation of the structural and optical characters of PVA/PVP blended films. Opt. Mater. 2020, 100, 109667. [Google Scholar] [CrossRef]
- Ghadermazi, R.; Hamdipour, S.; Sadeghi, K.; Ghadermazi, R.; Khosrowshahi Asl, A. Effect of various additives on the properties of the films and coatings derived from hydroxypropyl methylcellulose—A review. Food Sci. Nutr. 2019, 7, 3363–3377. [Google Scholar] [CrossRef]
- Om, S.; Amol, K. Carbomer: A comprehensive review. Inventi Rapid Pharm. Tech. 2016, 1, 1–8. [Google Scholar]
- Mayachiew, P.; Devahastin, S. Comparative evaluation of physical properties of edible chitosan films prepared by different drying methods. Dry. Technol. 2008, 26, 176–185. [Google Scholar] [CrossRef]
- Owusu-Ware, S.K.; Boateng, J.; Jordan, D.; Portefaix, S.; Tasseto, R.; Ramano, C.D.; Antonijević, M.D. Molecular mobility of hydroxyethyl cellulose (HEC) films characterised by thermally stimulated currents (TSC) spectroscopy. Int. J. Pharm. 2016, 497, 222–227. [Google Scholar] [CrossRef]
- Sharif, S.N.M.; Hashim, N.; Isa, I.M.; Bakar, S.A.; Saidin, M.I.; Ahmad, M.S.; Mamat, M.; Hussein, M.Z.; Zainul, R. The impact of a hygroscopic chitosan coating on the controlled release behaviour of zinc hydroxide nitrate–sodium dodecylsulphate–imidacloprid nanocomposites. New J. Chem. 2020, 44, 9097–9108. [Google Scholar] [CrossRef]
- Szabó, B.; Süvegh, K.; Zelkó, R. Real time positron annihilation lifetime spectroscopy for the detection of the hydrocolloid gel-film transition of polymers. Polym. Test. 2012, 31, 546–549. [Google Scholar] [CrossRef]
- Chen, H.J.; Lee, P.Y.; Chen, C.Y.; Huang, S.L.; Huang, B.W.; Dai, F.J.; Chau, C.F.; Chen, C.S.; Lin, Y.S. Moisture retention of glycerin solutions with various concentrations: A comparative study. Sci. Rep. 2022, 12, 10232. [Google Scholar] [CrossRef]
- Verhoeven, J.; Schaeffer, R.; Bouwstra, J.A.; Junginger, H.E. The physico-chemical characterization of poly(2-hydroxyethyl methacrylate-co-methacrylic acid): 2. Effect of water, PEG 400 and PEG 6000 on the glass transition temperature. Polymer 1989, 30, 1946–1950. [Google Scholar] [CrossRef]
- Liew, K.B.; Tan, Y.T.F.; Peh, K.K. Effect of polymer, plasticizer and filler on orally disintegrating film. Drug Dev. Ind. Pharm. 2014, 40, 110–119. [Google Scholar] [CrossRef]
- Eslami, Z.; Elkoun, S.; Robert, M.; Adjallé, K. A review of the effect of plasticizers on the physical and mechanical properties of alginate-based films. Molecules 2023, 28, 6637. [Google Scholar] [CrossRef]
- Proksch, E. pH in nature, humans and skin. J. Dermatol. 2018, 45, 1044–1052. [Google Scholar] [CrossRef]
- Schmid-Wendtner, M.H.; Korting, H.C. The pH of the skin surface and its impact on the barrier function. Skin Pharmacol. Physiol. 2006, 19, 296–302. [Google Scholar] [CrossRef]
- Burlando, B.; Cornara, L. Honey in dermatology and skin care: A review. J. Cosmet. Dermatol. 2013, 12, 306–313. [Google Scholar] [CrossRef]
- Suwiński, G.; Nowak, I. Innovative honey-based product and its beneficial effects measured by modern biophysical and imaging skin techniques. Pharmaceuticals 2024, 17, 1709. [Google Scholar] [CrossRef]
- Thewanjutiwong, S.; Phokasem, P.; Disayathanoowat, T.; Juntrapirom, S.; Kanjanakawinkul, W.; Chaiyana, W. Development of film-forming gel formulations containing royal jelly and honey aromatic water for cosmetic applications. Gels 2023, 9, 816. [Google Scholar] [CrossRef]
- Wang, Y.; Kuo, S.; Shu, M.; Yu, J.; Huang, S.; Dai, A.; Two, A.; Gallo, R.L.; Huang, C.M. Staphylococcus epidermidis in the human skin microbiome mediates fermentation to inhibit the growth of Propionibacterium acnes: Implications of probiotics in acne vulgaris. Appl. Microbiol. Biotechnol. 2014, 98, 411–424. [Google Scholar] [CrossRef] [PubMed]
- Nishio, E.; Ribeiro, J.; Oliveira, A.; Andrade, C.G.T.J.; Proni, E.A.; Kobayashi, R.K.T.; Nakazato, G. Antibacterial synergic effect of honey from two stingless bees: Scaptotrigona bipunctata Lepeletier, 1836, and S. postica Latreille, 1807. Sci. Rep. 2016, 6, 21641. [Google Scholar] [CrossRef]
- Chaiyana, W.; Rades, T.; Okonogi, S. Characterization and in vitro permeation study of microemulsions and liquid crystalline systems containing the anticholinesterase alkaloidal extract from Tabernaemontana divaricata. Int. J. Pharm. 2013, 452, 201–210. [Google Scholar] [CrossRef]
- Rauwel, E.; Arya, G.; Praakle, K.; Rauwel, P. Use of Aloe vera gel as media to assess antimicrobial activity and development of antimicrobial nanocomposites. Int. J. Mol. Sci. 2024, 25, 5599. [Google Scholar] [CrossRef]
- Sutjarittangtham, K.; Sanpa, S.; Tunkasiri, T.; Chantawannakul, P.; Intatha, U.; Eitssayeam, S. Bactericidal effects of propolis/polylactic acid (PLA) nanofibres obtained via electrospinning. J. Apic. Res. 2014, 53, 109–115. [Google Scholar] [CrossRef]

| Samples | Inhibition Zone (mm) | ||
|---|---|---|---|
| S. aureus | S. epidermidis | C. acnes | |
| Gentamicin (0.1 mg/mL) | 24.3 ± 2.3 a | 23.5 ± 0.5 c | 29.7 ± 2.5 b |
| Tetracycline (0.1 mg/mL) | 29.0 ± 2.2 a | 33.2 ± 0.8 a | 42.7 ± 1.2 a |
| DMSO (100%) | 0.0 ± 0.0 d | 0.0 ± 0.0 f | 0.0 ± 0.0 d |
| Salicylic acid (0.35% w/v) | 27.3 ± 0.8 a | 30.2 ± 0.8 b | 43.0 ± 1.0 a |
| Propolis extract (1% w/v) | 20.0 ± 1.0 a,b | 24.8 ± 0.3 c | 23.0 ± 1.0 c |
| Honey (1% w/v) | 10.8 ± 0.3 c | 14.2 ± 0.3 d | 0.0 ± 0.0 d |
| Royal jelly extract (1% w/v) | 8.3 ± 3.6 c | 10.3 ± 0.8 e | 0.0 ± 0.0 d |
| Combination of bee products | 17.8 ± 0.3 b | 29.0 ± 0.5 b | 40.8 ± 0.8 a |
| Film-Forming Agent | Concentration (% w/w) | pH | Viscosity (mPas) | Drying Time (min) |
|---|---|---|---|---|
| PVA | 5 | 5.5 | <1.0 i | 35.2 ± 0.2 j |
| 10 | 5.5 | <1.0 i | 25.0 ± 0.1 g | |
| 15 | 5.5 | 9.2 ± 0.1 d | 23.0 ± 0.1 e | |
| PVP | 5 | 5.0 | <1.0 i | 22.0 ± 0.1 d |
| 7 | 5.0 | <1.0 i | 20.1 ± 0.1 c | |
| 25 | 5.0 | 4.7 ± 0.4 f | 18.5 ± 0.1 a | |
| HPMC | 5 | 5.5 | 23.4 ± 0.5 a | 38.5 ± 0.1 k |
| Carbomer® 940 | 1 | 5.0 | 12.1 ± 0.4 c | 20.4 ± 0.1 c |
| Chitosan | 1 | 4.0 | <1.0 i | 22.0 ± 0.1 d |
| 3 | 5.0 | 7.7 ± 0.2 e | 28.3 ± 0.2 i | |
| 5 | 6.0 | 14.7 ± 0.9 b | 31.4 ± 0.3 | |
| Xanthan gum | 1 | 5.0 | 2.1 ± 0.1 h | 25.5 ± 0.2 g |
| 3 | 5.0 | 9.5 ± 0.3 d | 19.4 ± 0.1 b | |
| 5 | 5.0 | 15.4 ± 0.2 b | 18.1 ± 0.1 a | |
| HEC | 2 | 5.5 | 3.5 ± 0.3 g | 26.4 ± 0.1 h |
| 3 | 5.5 | 9.6 ± 0.1 d | 24.3 ± 0.1 f |
| Concentration (% w/w) | Visual Appearance | pH | Viscosity (mPas) | Drying Time (min) | ||
|---|---|---|---|---|---|---|
| PVA | Carbomer® 940 | Gel | Film | |||
| 5 | 1 | ![]() | ![]() | 4.5 | 17.0 ± 0.5 a | 14.2 ± 0.1 a |
| 5 | 0.75 | ![]() | ![]() | 4.5 | 14.8 ± 0.8 b | 16.4 ± 0.1 b |
| 5 | 0.50 | ![]() | ![]() | 4.5 | 10.7 ± 0.7 c | 16.3 ± 0.1 b |
| 5 | 0.25 | ![]() | ![]() | 4.5 | 3.3 ± 0.3 d | 21.3 ± 0.1 c |
| Concentration (% w/w) | Visual Appearance | pH | Viscosity (mPas) | Drying Time (min) | ||||
|---|---|---|---|---|---|---|---|---|
| PVA | Carbomer® 940 | PEG 400 | Glycerin | Gel | Film | |||
| 5 | 0.75 | - | - | ![]() | ![]() | 4.5 | 14.8 ± 0.8 e | 16.4 ± 0.1 g |
| 5 | 0.75 | 10 | - | ![]() | ![]() | 4.5 | 14.6 ± 0.1 e | 31.3 ± 0.1 e |
| 5 | 0.75 | 5 | - | ![]() | ![]() | 4.5 | 15.6 ± 0.1 d | 32.1 ± 0.1 d |
| 5 | 0.75 | 5 | 3 | ![]() | ![]() | 4.5 | 16.3 ± 0.1 c | 27.4 ± 0.1 f |
| 5 | 0.75 | - | 3 | ![]() | ![]() | 4.5 | 17.3 ± 0.3 b | 39.3 ± 0.1 a |
| 5 | 0.75 | - | 5 | ![]() | ![]() | 4.5 | 17.4 ± 0.3 b | 37.2 ± 0.1 b |
| 5 | 0.75 | - | 10 | ![]() | ![]() | 4.5 | 17.0 ± 0.2 b | 33.2 ± 0.1 c |
| Film-Forming Gel Formulation | pH | Viscosity (mPas) | Drying Time (min) |
|---|---|---|---|
| Blank | 4.5 | 16.3 ± 0.1 a | 27.4 ± 0.1 b |
| Propolis extract (1% w/v) | 5.5 | 15.3 ± 0.2 c | 25.2 ± 2.2 b |
| Honey (1% w/v) | 4.5 | 15.9 ± 0.4 a,b | 32.3 ± 5.0 a |
| Royal jelly extract (1% w/v) | 4.5 | 15.6 ± 0.1 b,c | 20.2 ± 1.3 c |
| Combination of bee products and salicylic acid | 5.0 | 16.6 ± 0.1 a | 31.3 ± 1.2 a |
| Film-Forming Gel Formulation | Bacterial Growth | ||
|---|---|---|---|
| S. aureus | S. epidermidis | C. acne | |
| Blank | ++ | − | ++++ |
| Propolis extract (1% w/v) | +++ | − | ++++ |
| Honey (1% w/v) | + | − | ++++ |
| Royal jelly extract (1% w/v) | + | + | ++++ |
| Combination of bee products and salicylic acid | − | − | ++++ |
Disclaimer/Publisher’s Note: The statements, opinions and data contained in all publications are solely those of the individual author(s) and contributor(s) and not of MDPI and/or the editor(s). MDPI and/or the editor(s) disclaim responsibility for any injury to people or property resulting from any ideas, methods, instructions or products referred to in the content. |
© 2025 by the authors. Licensee MDPI, Basel, Switzerland. This article is an open access article distributed under the terms and conditions of the Creative Commons Attribution (CC BY) license (https://creativecommons.org/licenses/by/4.0/).
Share and Cite
Somwongin, S.; Tammasorn, P.; Limbunjerd, R.; Norkaew, K.; Lertprachyakorn, N.; Kongsaeng, T.; Phokasem, P.; Disayathanoowat, T.; Lin, W.-C.; Chaiyana, W. Bee Product-Based Antimicrobial Film-Forming Gels Targeting Staphylococcus aureus, Staphylococcus epidermidis, and Cutibacterium acnes for Anti-Acne Applications. Gels 2025, 11, 802. https://doi.org/10.3390/gels11100802
Somwongin S, Tammasorn P, Limbunjerd R, Norkaew K, Lertprachyakorn N, Kongsaeng T, Phokasem P, Disayathanoowat T, Lin W-C, Chaiyana W. Bee Product-Based Antimicrobial Film-Forming Gels Targeting Staphylococcus aureus, Staphylococcus epidermidis, and Cutibacterium acnes for Anti-Acne Applications. Gels. 2025; 11(10):802. https://doi.org/10.3390/gels11100802
Chicago/Turabian StyleSomwongin, Suvimol, Pattiya Tammasorn, Ratthaporn Limbunjerd, Kankamon Norkaew, Nattakan Lertprachyakorn, Thanaphorn Kongsaeng, Patcharin Phokasem, Terd Disayathanoowat, Wei-Chao Lin, and Wantida Chaiyana. 2025. "Bee Product-Based Antimicrobial Film-Forming Gels Targeting Staphylococcus aureus, Staphylococcus epidermidis, and Cutibacterium acnes for Anti-Acne Applications" Gels 11, no. 10: 802. https://doi.org/10.3390/gels11100802
APA StyleSomwongin, S., Tammasorn, P., Limbunjerd, R., Norkaew, K., Lertprachyakorn, N., Kongsaeng, T., Phokasem, P., Disayathanoowat, T., Lin, W.-C., & Chaiyana, W. (2025). Bee Product-Based Antimicrobial Film-Forming Gels Targeting Staphylococcus aureus, Staphylococcus epidermidis, and Cutibacterium acnes for Anti-Acne Applications. Gels, 11(10), 802. https://doi.org/10.3390/gels11100802























